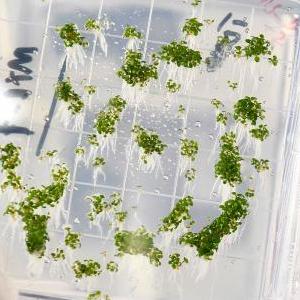

1月7日,在位于济南市的山东省农科院蔬菜研究所,阿里·安沃(左)和生物技术团队人员讨论。
巴基斯坦留学生阿里·安沃2016年来到中国,在中国农科院蔬菜花卉研究所取得博士学位后,2021年又来到位于济南市的山东省农科院蔬菜研究所进行博士后研究进修。
阿里说,山东是农业科技大省,他希望将自己学到的先进蔬菜种植技术应用到巴基斯坦的农业产业发展中,以蔬菜科技为纽带,做中巴友谊的见证者和传播者。
新华社记者 郭绪雷 摄

【纠错】
【责任编辑:刘笑冬
】

1月7日,在位于济南市的山东省农科院蔬菜研究所,阿里·安沃(左)和生物技术团队人员讨论。
巴基斯坦留学生阿里·安沃2016年来到中国,在中国农科院蔬菜花卉研究所取得博士学位后,2021年又来到位于济南市的山东省农科院蔬菜研究所进行博士后研究进修。
阿里说,山东是农业科技大省,他希望将自己学到的先进蔬菜种植技术应用到巴基斯坦的农业产业发展中,以蔬菜科技为纽带,做中巴友谊的见证者和传播者。
新华社记者 郭绪雷 摄